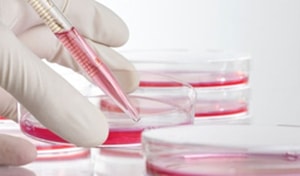
анализы крови для спортсменов

Анализы МРТ, УЗИ и ЭКГ, рекомендуемые к сдаче перед походом в зал, здоровому человеку будут лишними. А людям с нарушениями итак ясно, что требуется лечение, а не поход в спортзал. А вот предрасположенность к спорту по анализам крови определяется 3-мя тестами, которые расскажут об индивидууме.
Анализы крови для спортсменов
Речь пойдет о гормональных анализах, которые выполняются в специализированных клиниках по забору крови из вены. Атлету понадобится пролактин, общий тестостерон и эстрадиол — анализы крови для спортсменов женского и мужского пола. Отдельно стоит упомянуть о подготовке к сдаче, отсутствие которой способно видоизменить картину по сданным тестам, улучшив или ухудшив результаты.
Речь пойдет о гормональных анализах, которые выполняются в специализированных клиниках по забору крови из вены. Атлету понадобится пролактин, общий тестостерон и эстрадиол — анализы крови для спортсменов женского и мужского пола. Отдельно стоит упомянуть о подготовке к сдаче, отсутствие которой способно видоизменить картину по сданным тестам, улучшив или ухудшив результаты.
- Анализ крови на гормоны сдается утром на пустой желудок. Врачи не рекомендуют даже пить воду, которая негативно влияет на вывод крови из вены, при отборе.
- А вот поход в туалет по нуждам перед сдачей анализов приветствуется, ведь очищение организма нормализует обмен веществ.
- За 3 дня перед сдачей анализов, врачи рекомендуют исключить алкоголь, тренировки и секс.
Общий тестостерон
Анализы для бодибилдеров строятся на секреции тестостерона. Чем больше показатель – тем больше вероятность развить собственное тело, увеличив мышечную массу. Как правило, у тучных людей с жировыми запасами, общий тестостерон расположен на нижней границе норматива:
- для мужчин интервал 200 — 800 нг/дл;
- для женщин 2 – 50 нг/дл.
Заметьте, расчет ведется в нг/дл, однако, с помощью калькулятора, можно данные перевести в другие единицы измерений, например в нмоль/л. Показатели в клиниках иногда варьируются, а сам диапазон сокращается. Как показывает практика, изменение норм на руку клиникам, которые тут же предложат лечение гормональной системы, обозначив проблемы в половых органах. В таких случаях, анализы крови для спортсменов рекомендуется сдать еще раз в другой клинике.
Шаг назад
Пролактин считается женским гормоном, превышение которого в организме наглядно демонстрирует спортсмену не мужские половые признаки. Начиная с груди по женскому типу, заканчивая податливым и тихим нравом. Пролактин – враг тестостерона, однако нельзя провести аналог с добром и злом. Пролактин всё-таки требуется мужскому организму, так как участвует в обмене веществ и регулировании аминокислотного баланса. Нормы:
- для мужчин 2,5 – 15 нг/мл;
- для женщин 2 – 25 нг/мл.
Анализы крови для спортсменов включают пролактин. Результаты нужны для выявления проблемы в гормональной системе. В сравнении с заниженным показателем общего тестостерона, повышенный пролактин легко снизить. Причем лечение и тренировки в спортивном зале друг другу не мешают. А чаще, при похудении, улучшают результат.
Страшный зверь
 В анализы крови для спортсменов включают эстрадиол. Гормон мужчины в народе, величают эстрогеном и страшно боятся, когда показатель превышает установленную норму – свыше 56 пг/мл. Но зверь не так страшен, как рисуют. Ведь эстроген контролирует рост мышечных тканей и функционирование половой системы. Без эстрогена нет росту костей и суставов. Поэтому спортсмену остается держать гормон в пределах нормы.
В анализы крови для спортсменов включают эстрадиол. Гормон мужчины в народе, величают эстрогеном и страшно боятся, когда показатель превышает установленную норму – свыше 56 пг/мл. Но зверь не так страшен, как рисуют. Ведь эстроген контролирует рост мышечных тканей и функционирование половой системы. Без эстрогена нет росту костей и суставов. Поэтому спортсмену остается держать гормон в пределах нормы.
В заключение
Выяснив, какие гормоны сдают спортсмены, можно смело приступать к трехдневной подготовке организма и поиску клиники по забору крови. Эксперты рекомендуют не жадничать на анализах и ежегодно выполнять подобное тестирование даже физически развитым и здоровым людям.


